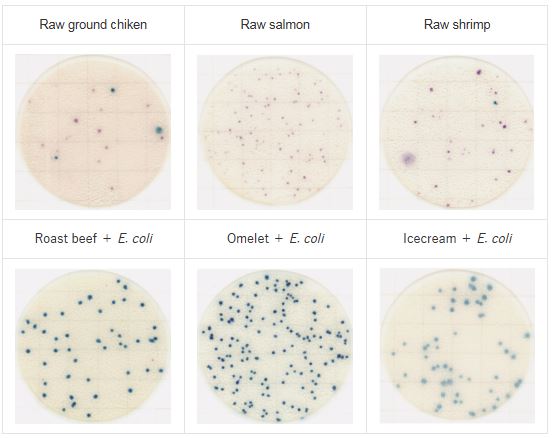
Food sample testing on Easy Plate EC

Film medium for E. coli counts | Easy Plate EC Kikkoman
1. Introduction to Easy Plate
- Easy Plate is a ready-to-use culture medium, convenient and sterilization-free. Easy Plate is an easy-to-use alternative to traditional culture plates prepared in-house, helping to save time, effort, and reduce waste.
- Easy Plate EC is a microbial culture plate developed by Kikkoman Biochemifa (Japan). This is a ready-to-use dry medium plate, specifically designed for the detection and enumeration of Coliforms and Escherichia coli (E. coli) in food, drinking water, and other testing samples.
- The plate has a compact size (55 mm), easy to use, requiring no media preparation or sterilization, which helps shorten testing time and optimize laboratory workflow.
- Using Easy Plate as a food microbiological testing tool – with a volume of only about 1/20 that of a conventional petri dish – saves incubator space and allows more tests to be performed with the same incubator capacity. Easy Plate comes pre-packaged, and once the package is opened, you can simply apply the sample suspension onto the medium and begin incubation.
- The plate is designed as a dry medium sheet, already fixed and ready to use immediately without media preparation or sterilization.

2. Specifications Easy Plate EC
- Product name: Easy Plate EC
- Product code: 61975
- Application: Rapid testing of E. coli and Coliform
- Incubation time: 24 ± 1 hours
- Incubation temperature: 35 ± 1℃
- Storage condition (unopened): 2 – 8℃
- After opening: Fold the opened edge of the package at least twice and seal with tape. Store in the refrigerator (2 – 8℃) and use within 3 months.
- Shelf life: 18 months from the manufacturing date
- Certification: AOAC RI PTM certified (License No. 031601).
3. Principle
- Selective principle: Easy Plate EC contains selective inhibitors that allow Coliforms and E. coli to grow while suppressing unwanted microorganisms.
- Colony identification and counting are easier compared to other media such as traditional agar, since colonies are colorized – there is no need to confirm the presence/absence of gas bubbles or colony size.

- High correlation with traditional agar plates across various food types.

- E. coli O157:H7 colonies: While most E. coli produce β-glucuronidase, E. coli O157:H7 does not, and therefore appears as purple-red colonies similar to Coliforms.

- Plate surface coloration caused by enzymes present in food: In some foods and unheated dairy products, residual enzymes may cause purple-red coloration across the entire incubation area. If colony visibility is affected, improved results can be obtained by using dilution solutions.

4. Benefits
Compared with traditional pour plate methods, Easy Plate EC offers several outstanding benefits:
- Convenient and fast: Ready-to-use without media preparation, saving laboratory time.
- Simple handling: Just add 1 mL of sample directly onto the plate, cover with the film, and incubate at the specified temperature.
- Clear and easy-to-read results: Coliforms and E. coli colonies are displayed in distinct colors, making them easy to distinguish and count.
- High testing efficiency: Internationally standardized, ensuring accuracy and reproducibility.
- Space-saving storage: Compact plates can be stored refrigerated and are easy to transport.
- Safe and clean: Minimizes exposure to liquid culture media, reducing the risk of cross-contamination.
5. Applications
Easy Plate EC is widely applied in various fields, particularly in food safety and drinking water quality control:
- Food: meat, seafood, dairy and dairy products, confectionery, processed vegetables and fruits, packaged foods.
- Drinking water and beverages: quality assessment of bottled water, purified water, and soft drinks.
- Pharmaceuticals and cosmetics: hygiene testing as part of quality management.
- Testing and research institutions: laboratories, inspection centers, and universities.
6. Examples
- Reference strains of E. coli and Coliform on Easy Plate EC.

- Food sample testing on Easy Plate EC for E. coli and Coliform.
Pacific Science Technology Euquipment Co.,LTD is the official distributor of Easy Plate products from Kikkoman in Vietnam. Please contact us for quotations and detailed product information.







